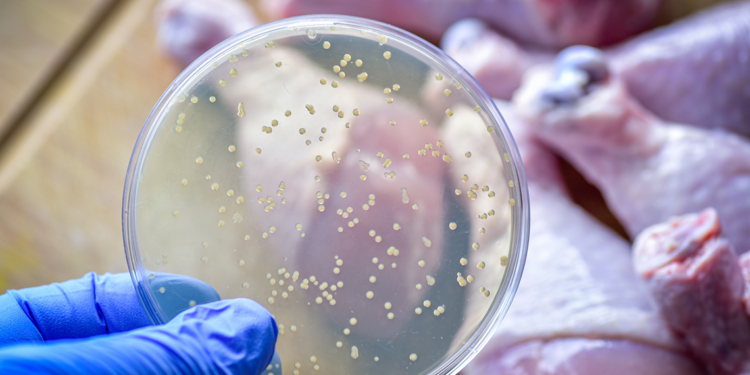
Prof. Dr. Yaşar Bayındır’dan salmonella enfeksiyonu uyarısı

Enfeksiyon Hastalıkları Uzmanı Prof. Dr. Yaşar Bayındır, “salmonella enfeksiyonu, özellikle yaz ve sonbahar aylarında ciddi bir artış gösteriyor” dedi.
Gıda kaynaklı enfeksiyonların başında gelen salmonella enfeksiyonları, özellikle yaz ve sonbahar aylarında ciddi bir artış gösteriyor. Türkiye’de gıda hijyeninin sağlanmasının halk sağlığı açısından önemini vurgulayan Güven Hastanesi Enfeksiyon Hastalıkları Uzmanı Prof. Dr. Yaşar Bayındır, salmonella enfeksiyonu (salmonelloz) ile ilgili açıklamalarda bulundu. Özellikle hızlı tüketim ürünleri ve açıkta satılan yiyecekler üzerinden bakterinin hızla yayılabileceğine dikkat çeken Prof. Dr. Bayındır, vatandaşlara hijyen kurallarına azami özen göstermeleri konusunda uyarılarda bulundu.
Salmonella enfeksiyonlarının, iyi pişirilmemiş et, tavuk ve yumurta gibi gıdalardan bulaşabildiğini kaydeden Prof. Dr. Yaşar Bayındır, kirli su ve yetersiz hijyen koşullarında hazırlanan yiyeceklerle de insan sağlığını tehdit ettiğini belirterek, “Bu bakterinin özellikle restoranlar, kafeler, sokak satıcıları ve evlerde hijyen standartlarına uyulmadığında hızlı bir şekilde yayılabildiğini gözlemliyoruz” diye konuştu.
‘BELİRTİLER CİDDİYE ALINMALI’
Salmonella enfeksiyonlarının belirtileri hakkında da bilgi veren Prof. Dr. Bayındır, yüksek ateş, karın ağrısı, bulantı, kusma ve ishal gibi semptomların dikkate alınması gerektiğini belirterek, “Bu tür belirtiler, özellikle bağışıklığı zayıf kişilerde daha ağır seyredebiliyor ve hayati risk taşıyabiliyor. Bu nedenle belirtileri gösteren kişilerin vakit kaybetmeden bir sağlık kuruluşuna başvurmaları çok önemli. Özellikle küçük çocuklar, yaşlılar ve kronik hastalığı olanlar Salmonella bakterilerinden daha fazla etkileniyor. Enfeksiyon, hızlı müdahale edilmediğinde ciddi komplikasyonlara yol açabiliyor” dedi.
‘HIZLI TÜKETİM GIDALARINA DİKKAT’
Son yıllarda artan hızlı tüketim (fast food) alışkanlığının, salmonella enfeksiyonlarının yayılmasına zemin hazırladığını söyleyen Prof. Dr. Bayındır, “Hızlı tüketim gıdaları, yoğun şekilde hazırlanan ve çoğu zaman hızlı pişirme yöntemleriyle servis edilen ürünler olduğu için bakterilerin bu gıdalarda çoğalma ve bulaşma riskini artırabiliyor. Bu gıdaların hijyenik ortamlarda ve doğru pişirme teknikleriyle hazırlanması çok önemli” ifadelerini kullandı. Sokak satıcılarından ya da hızlı tüketim restoranlarından alınan yiyeceklerin hijyen koşullarına dikkat edilmeden hazırlandığında bakterilerin çoğalması için uygun bir ortam oluşturduğunu belirten Prof. Dr. Bayındır, “Bu tür gıdaların tüketiminde seçici davranılmalı ve mümkünse güvenilir yerlerden alışveriş yapılmalı” diye konuştu.
‘HERKESİN ALABİLECEĞİ BASİT ÖNLEMLER’
Prof. Dr. Bayındır, salmonella enfeksiyonlarına karşı alınabilecek önlemler ile ilgili, “Taze ve temiz gıda tüketimine özen göstermek, gıdaları iyice pişirerek tüketmek ve yemek hazırlarken her kirlenmede ya da iş değişiminde sık sık elleri yıkamak en etkili korunma yöntemleridir. Özellikle yumurta, tavuk ve et ürünlerinin hijyen standartlarına uygun olarak pişirilmesi gerekiyor. Bunun yanı sıra buzdolabında uzun süre saklanan gıdalar konusunda bozulma riskine karşı dikkatli olunması gerekiyor. Evde yemek hazırlarken dahi sebze ve meyvelerin iyice yıkanması, pişirme ve saklama koşullarına dikkat edilmesi, bakteri bulaşmasını büyük oranda engelleyebilir. Ayrıca mutfakta yıkama işlemleri yapılırken kirli suyun sıçrayabilme olasılığı nedeniyle lavaboya yakın açıkta gıdalar da bırakılmamalıdır” dedi.
‘TOPLUMSAL FARKINDALIK ÖNEM TAŞIYOR’
Toplum sağlığının korunması adına herkesin bu konuda bilinçli ve dikkatli olması gerektiğinin altını çizen Prof. Dr. Yaşar Bayındır, “Hepimizin sağlığını korumak için bu enfeksiyonla ilgili gerekli önlemleri almak, toplumsal farkındalığı artırmak ve hijyen kurallarına özen göstermek büyük önem taşıyor. Aslında Covid-19 pandemisiyle deneyimlediğimiz gibi alınan önlemler sadece bir enfeksiyona değil aynı anda birçok enfeksiyondan korunmayı mümkün hale getirmekte, sadece bireyin değil toplumun sağlığı korunmuş olmaktadır” diye konuştu.